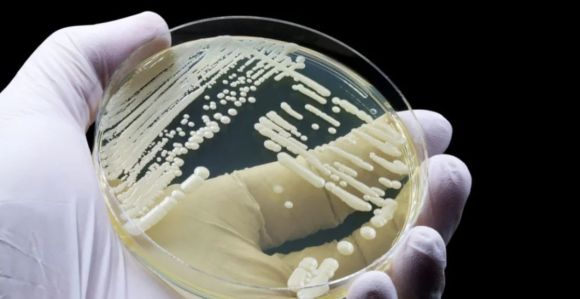
Superfungo Candida auris

Superfungo Candida auris: teste criado na UFMG tem registro aprovado e poderá ser usado em hospitais
O teste foi desenvolvido com a orientação de pesquisadores do INCT Leveduras, no Insituto de Ciências Biológicas da UFMG
Uma nova opção de teste para o superfungo Candida auris criado na Universidade Federal de Minas Gerais (UFMG) teve o registro aceito no Insituto Nacional da Propriedade Industrial (INPI) e, em breve, poderá ser usado no Hospital João XXIII, onde pacientes com o fungo são tratados.
O teste foi desenvolvido com a orientação de pesquisadores do INCT Leveduras, no Insituto de Ciências Biológicas da UFMG. Ele consiste em um meio de cultura chamado Candida auris Selective, ou CAS, e pode ajudar no controle de infecções hospitalares.
O CAS oferece nutrientes para que o fungo, uma levedura renomeada como Candidozyma auris, cresça em ambiente controlado, inibindo outras espécies de leveduras oportunistas. Os testes tem 92,9% de sensibilidade e 100% de especificidade para a Candida auris, de acordo com a bióloga Susana Johann.
Além de Johann, participam do desenvolvimento a farmacêutica Viviane Cata Preta de Souza, o professor Carlos Augusto Rosa, orientador, e Raquel Basques Caligiorne, co-orientadora. O teste pode ser rápido e de baixo custo.
O que é o superfungo Candida auris?
Candida auris é um fungo que apresenta uma “grave ameaça à saúde global” que foi identificado pela primeira vez em 2009, no Japão, de acordo com a Biblioteca Virtual em Saúde, do Ministério da Saúde.
Ele é uma ameaça à saúde pública porque tem a capacidade de resistir aos principais medicamentos antifúngicos existentes nos dias atuais. Os sintomas mais comuns dele, segundo o Centro de Controle e Prevenção de Doenças (CDC) dos EUA, são febre e calafrios.
Para identificá-lo, são necessários métodos laboratoriais específicos, uma vez que ele pode ser facilmente confundido com outros fungos, como Candida haemulonii e Saccharomyces cerevisiae.
Em Belo Horizonte, até esta quinta-feira (24), foram registrados quatro casos de Candida auris no Hospital João XXIII. Dois deles tiveram alta nos dias 20/9 e 2/10, um está internado e outro morreu. Esse último estava em estado grave devido a um acidente automobilístico, portanto, a morte "não tem relação com o fungo, segundo a SES-MG.
Até o momento, 40 pacientes foram testados, sendo:
- 4 confirmados;
- 6 negativados que permanecem internados;
- 5 negativados que já receberam alta;
- 25 que aguardam o resultado dos exames.
Formada pela PUC Minas, Maria Fernanda Ramos é repórter das editorias Minas Gerais, Brasil e Mundo na Itatiaia. Antes, passou pelo portal R7, da Record.



